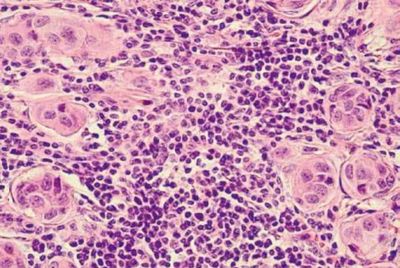

Remote detection and identification of Chemical Warfare Aerosols

Fly away remote sensor for Chemical Warfare Aerosols

PAT's infrared hyperspectral cameras are small enough for the dismount
We see the future of hyperspectral imaging to be used in medical diagnostics for the detection of early stage cancer. Application is detection skin cancer right in the doctors office in real-time replacing current approaches that take hours to days to determine clear margins
Copyright © 2023 Pacific Advanced Technology - All Rights Reserved.
Powered by GoDaddy Website Builder